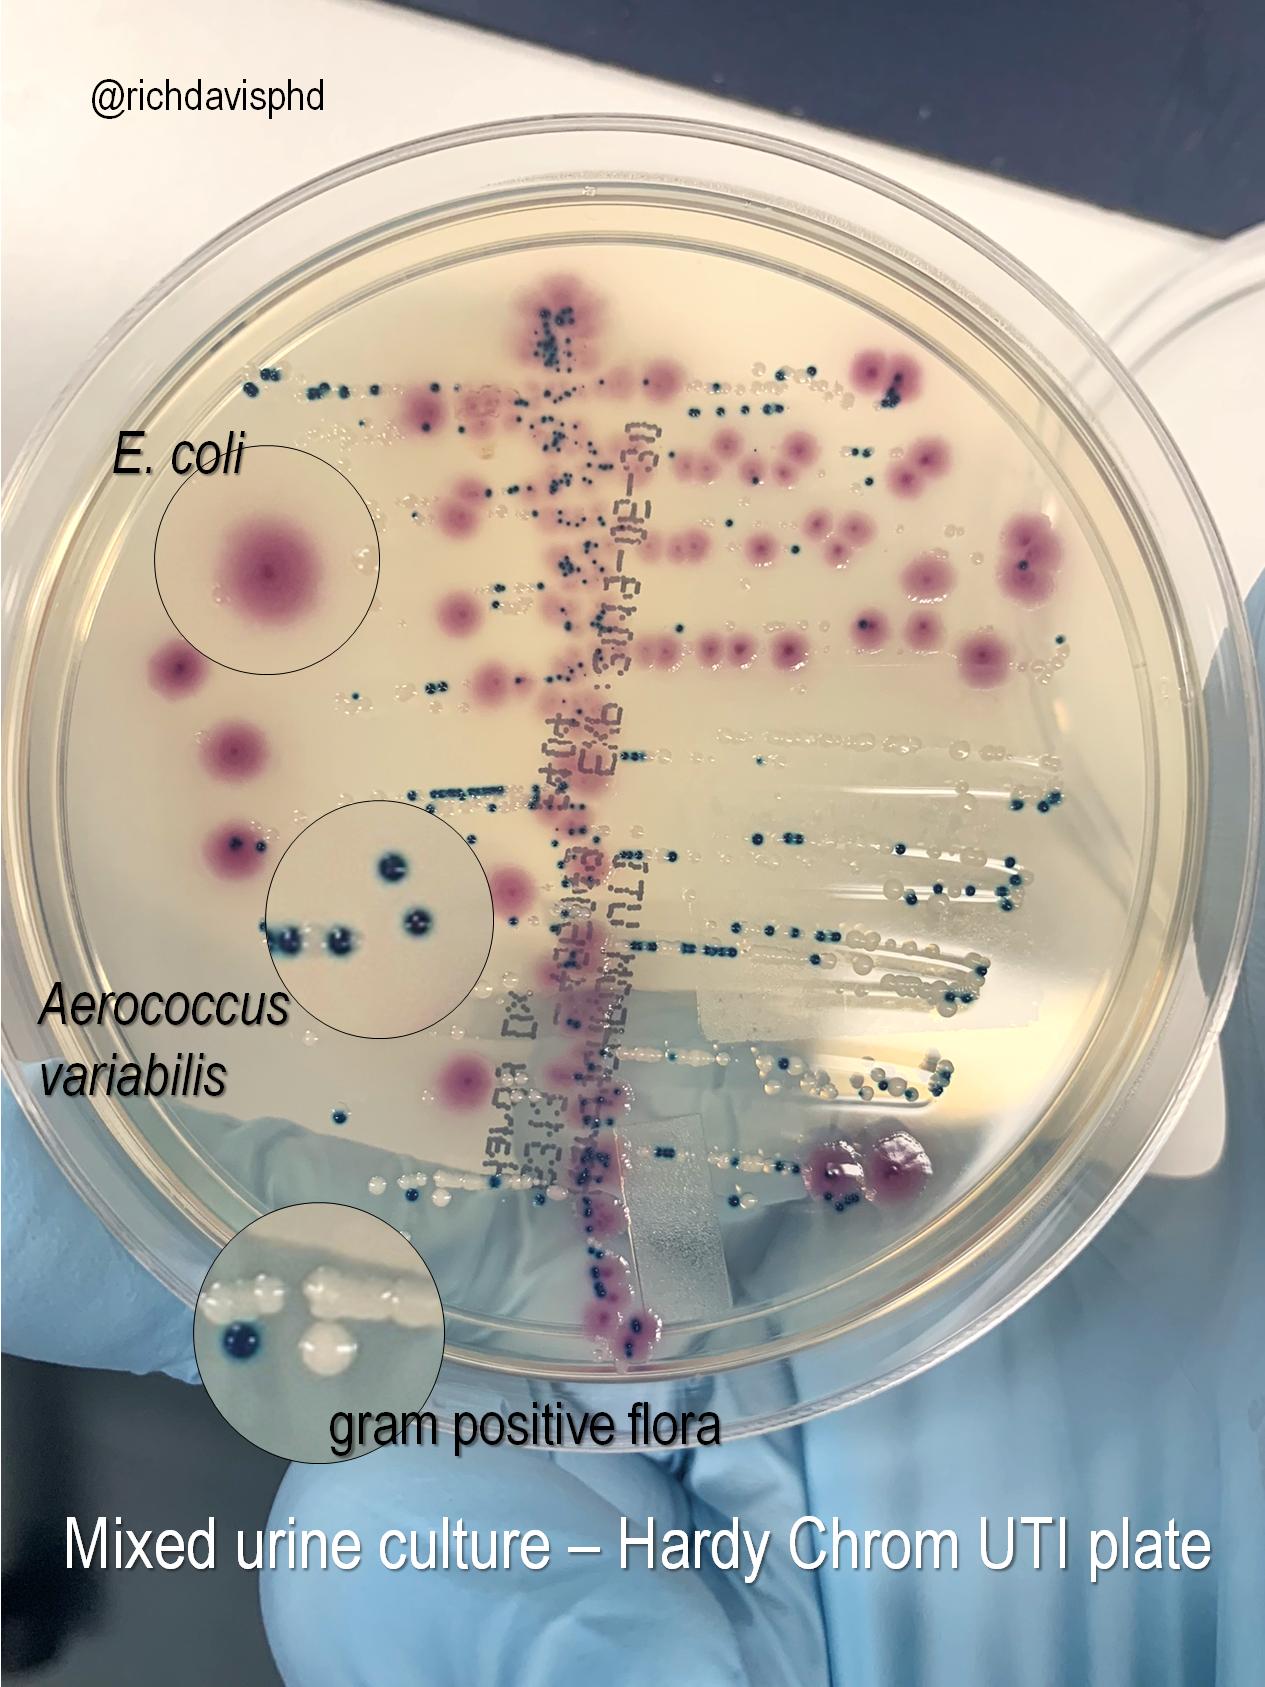
Rich Davis Phd D Abmm Mls Tren Twitter Microrounds Day 449 Mixed Results Urine Culture Plate On Chromogenic Agar Mauve E Coli Teal Usually Enterococcus But This Turned Out To Be

Your Urine culture mixed flora images are ready. Urine culture mixed flora are a topic that is being searched for and liked by netizens now. You can Download the Urine culture mixed flora files here. Get all royalty-free photos.
If you’re searching for urine culture mixed flora images information related to the urine culture mixed flora interest, you have pay a visit to the right site. Our website frequently gives you hints for downloading the maximum quality video and picture content, please kindly surf and find more informative video content and graphics that fit your interests.
Urine Culture Mixed Flora. I Intermediate. For a urine culture a small sample of urine is placed on one or more agar plates a thin layer of a nutrient media and incubated at body temperature. Have you seen a doctor about this yet. Urine normally should contain salt water and waste products.
 Id Core Curriculum Urine Cultures Ppt Video Online Download From slideplayer.com
Id Core Curriculum Urine Cultures Ppt Video Online Download From slideplayer.com
The same is true for perineal flora normal flora and vaginal flora. If there is infection then there should be more then 100000 colonies of one bacteria but if there are 2-3 different organisms in urine culture then it is called mixed flora and we generally recommend to repeat urine culture for better accuracy. Yes I take 500 mg of Keflex daily as a preventative. Any bacteria or yeast that are present in the urine sample grow over the next 24 to 48 hours. The distal urethra contains a sparse mixed flora. Mixed flora in the urine as a result also does not necessarily imply an infection or cause unless the provider has specifically stated so.
These organisms are present in urine specimens 104ml unless.
What does this means. If I am understanding mixed Flora correctly I believe it is bacteria contamination. Such a urine culture cannot be used to meet the NHSN UTI criteria. R Resistant Positive. What does urogenital flora present mean. N Negative MICS are expressed in micrograms per mL Antibiotic RSLTI RSLT2 RSLT3 Amoxicillin Clavulanic Acid Ämpici11in Cefazolin Cefepime Ceftriaxone Cefuroxime Cephalothin.
 Source: researchgate.net
Source: researchgate.net
Such a urine culture cannot be used to meet the NHSN UTI criteria. Such a urine culture cannot be utilized to meet the NHSN UTI criteria. Mixed growth consistent with normal urethral flora. Urine culture states mixed urogenital flora 50000 - 100000 colony forming units per ml. Mixed urogenital flora 25 000-50 000 colony forming units per ml Antimicrobial Susceptibility Susceptible.
 Source: researchgate.net
Source: researchgate.net
If there is infection then there should be more then 100000 colonies of one bacteria but if there are 2-3 different organisms in urine culture then it is called mixed flora and we generally recommend to repeat urine culture for better accuracy. Urine normally should contain salt water and waste products. 50000 is a higheramount of bacteria colonies present the desirable amount isusually under. Such a urine culture cannot be used to meet the NHSN UTI criteria. These organisms are present in urine specimens 104ml unless.
 Source: howtodiscuss.com
Source: howtodiscuss.com
Urine normally should contain salt water and waste products. Such a urine culture cannot be utilized to meet the NHSN UTI criteria. What does this means. The same is true for perineal flora normal flora and vaginal flora. Urine culture was done showed 10000-25000 cfu mixed with urogenital flora probably inconclusi.
 Source: youtube.com
Source: youtube.com
These organisms are present in urine specimens 104ml unless. Sometimes bacteria will get in the cup before you can urinate in it or bacteria from the moist toweltte or even skin bacteria which isnt a big deal. What does urogenital flora present mean. Urine normally should contain salt water and waste products. N Negative MICS are expressed in micrograms per mL Antibiotic RSLTI RSLT2 RSLT3 Amoxicillin Clavulanic Acid Ämpici11in Cefazolin Cefepime Ceftriaxone Cefuroxime Cephalothin.
 Source: slideplayer.com
Source: slideplayer.com
Actually a mixed bacterial flora result in a urine culture is usually indicative of contamination of the culture itself. Mixed urogenital flora refers to a test done on urine toidentify the bacteria present in the urine. Because mixed flora means that at least 2 organisms are present in addition to the identified organism such a urine culture does not meet the criteria for a positive urine culture with 2 organisms or less. What does this means. If I am understanding mixed Flora correctly I believe it is bacteria contamination.
 Source: community.babycenter.com
Source: community.babycenter.com
These organisms are present in urine specimens 104ml unless. Urine normally should contain salt water and waste products. If there is infection then there should be more then 100000 colonies of one bacteria but if there are 2-3 different organisms in urine culture then it is called mixed flora and we generally recommend to repeat urine culture for better accuracy. Urine culture states mixed urogenital flora 50000 - 100000 colony forming units per ml. Mixed flora in the urine as a result also does not necessarily imply an infection or cause unless the provider has specifically stated so.
 Source: teslascans.com
Source: teslascans.com
They are normal urethral flora andor colonizing bacteria from the skin vaginal or rectal areas. Urine culture was done showed 10000-25000 cfu mixed with urogenital flora probably inconclusi. Let your doctor decide what to do as it is the whole picture which decides the correct actions. 50000 is a higheramount of bacteria colonies present the desirable amount isusually under. What does urogenital flora present mean.
 Source: nejm.org
Source: nejm.org
N Negative MICS are expressed in micrograms per mL Antibiotic RSLTI RSLT2 RSLT3 Amoxicillin Clavulanic Acid Ämpici11in Cefazolin Cefepime Ceftriaxone Cefuroxime Cephalothin. Let your doctor decide what to do as it is the whole picture which decides the correct actions. Urine culture states mixed urogenital flora 50000 - 100000 colony forming units per ml. In mixed cultures except for S. The distal urethra contains a sparse mixed flora.

Mixed urine flora. Such a urine culture cannot be used to meet the NHSN UTI criteria. The same is true for perineal flora normal flora and vaginal flora. What medications are you taking. Second round of anti.
 Source: researchgate.net
Source: researchgate.net
Mixed urine flora. Because mixed flora implies that at least 2 organisms are present in addition to the identified organism the urine culture does not meet the criteria for a positive urine culture with 2 organisms or less. Urine culture states mixed urogenital flora 50000 - 100000 colony forming units per ml. But the general answer to this question is a mixed flora in the urine culture means the urine sample is polluted by bacteria from other parts of your body. Urine cultures that contain more than one organism are usually considered contaminated.
 Source: reddit.com
Source: reddit.com
Surprisingly few studies have evaluated the clinical significance of polymicrobial growth from urine. Found WBC100 and RBC between 5-10. But the general answer to this question is a mixed flora in the urine culture means the urine sample is polluted by bacteria from other parts of your body. Have you seen a doctor about this yet. Urogenital Flora Transient organisms eg Candida spp frequently cause vaginitis.
 Source: quora.com
Source: quora.com
I Intermediate. Urine culture was done showed 10000-25000 cfu mixed with urogenital flora probably inconclusi. Saprophyticus These organisms are not normally considered potential uropathogens. Such a urine culture cannot be utilized to meet the NHSN UTI criteria. If you have symptoms like fever often having to urinate or a burning pain when and after urimating you should have a new urine sample taken and be instructed how to take it.
 Source: slideplayer.com
Source: slideplayer.com
But the general answer to this question is a mixed flora in the urine culture means the urine sample is polluted by bacteria from other parts of your body. The frequency with which such growth truly represents mixed infection is unknown. Such a urine culture cannot be utilized to meet the NHSN UTI criteria. The significance of urine culture with mixed flora. If there is infection then there should be more then 100000 colonies of one bacteria but if there are 2-3 different organisms in urine culture then it is called mixed flora and we generally recommend to repeat urine culture for better accuracy.
 Source: pharmacology2000.com
Source: pharmacology2000.com
The same is true for perineal flora normal flora and vaginal flora. N Negative MICS are expressed in micrograms per mL Antibiotic RSLTI RSLT2 RSLT3 Amoxicillin Clavulanic Acid Ämpici11in Cefazolin Cefepime Ceftriaxone Cefuroxime Cephalothin. What does this means. Let your doctor decide what to do as it is the whole picture which decides the correct actions. Since a urine culture is a clinical lab not a pathology interpretation the result should not be used for coding since it is not a physician diagnostic statement.
 Source: researchgate.net
Source: researchgate.net
Mixed urogenital flora refers to a test done on urine toidentify the bacteria present in the urine. Second round of anti. Mixed urogenital flora refers to a test done on urine toidentify the bacteria present in the urine. Because mixed flora means that at least 2 organisms are present in addition to the identified organism such a urine culture does not meet the criteria for a positive urine culture with 2 organisms or less. N Negative MICS are expressed in micrograms per mL Antibiotic RSLTI RSLT2 RSLT3 Amoxicillin Clavulanic Acid Ämpici11in Cefazolin Cefepime Ceftriaxone Cefuroxime Cephalothin.
Saprophyticus These organisms are not normally considered potential uropathogens. These organisms are present in urine specimens 104ml unless. Up to 20 cash back basically Some week ago I had some flank pain they tested urine. Have you seen a doctor about this yet. The distal urethra contains a sparse mixed flora.
 Source: reddit.com
Source: reddit.com
Since a urine culture is a clinical lab not a pathology interpretation the result should not be used for coding since it is not a physician diagnostic statement. Any bacteria or yeast that are present in the urine sample grow over the next 24 to 48 hours. Yes I take 500 mg of Keflex daily as a preventative. But the general answer to this question is a mixed flora in the urine culture means the urine sample is polluted by bacteria from other parts of your body. Mixed flora in the urine as a result also does not necessarily imply an infection or cause unless the provider has specifically stated so.
 Source: researchgate.net
Source: researchgate.net
Any bacteria or yeast that are present in the urine sample grow over the next 24 to 48 hours as small circular colonies. N Negative MICS are expressed in micrograms per mL Antibiotic RSLTI RSLT2 RSLT3 Amoxicillin Clavulanic Acid Ämpici11in Cefazolin Cefepime Ceftriaxone Cefuroxime Cephalothin. Mixed urogenital flora refers to a test done on urine toidentify the bacteria present in the urine. Mixed urogenital flora 25 000-50 000 colony forming units per ml Antimicrobial Susceptibility Susceptible. Let your doctor decide what to do as it is the whole picture which decides the correct actions.
This site is an open community for users to do submittion their favorite wallpapers on the internet, all images or pictures in this website are for personal wallpaper use only, it is stricly prohibited to use this wallpaper for commercial purposes, if you are the author and find this image is shared without your permission, please kindly raise a DMCA report to Us.
If you find this site value, please support us by sharing this posts to your preference social media accounts like Facebook, Instagram and so on or you can also bookmark this blog page with the title urine culture mixed flora by using Ctrl + D for devices a laptop with a Windows operating system or Command + D for laptops with an Apple operating system. If you use a smartphone, you can also use the drawer menu of the browser you are using. Whether it’s a Windows, Mac, iOS or Android operating system, you will still be able to bookmark this website.






